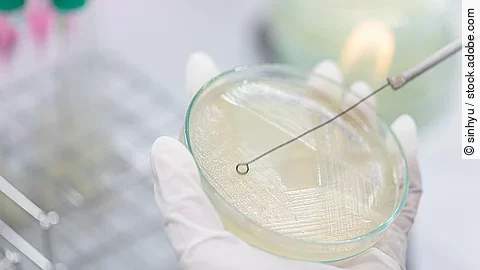

Aktualisierte Version des Artikels vom 13.5.2022
Deutlich mehr Fälle in den letzten Jahren
In einer Studie im Auftrags des Skandinavischen Ministerrats konnten vermehrt Fälle von alpha-Chloralose-Vergiftungen in 3 nordischen Ländern nachgewiesen werden. So wurden in Norwegischen Tierkliniken insgesamt 30 Fälle bei Hunden und Katzen im Zeitraum von Dezember 2019 bis Juni 2020 nachgewiesen. Die schwedische Universitätsklinik für Kleintiere meldete von Januar 2014 bis Februar 2020 80 Verdachts- und 25 bestätitgte Fälle. Finnland meldete fast doppelt so viele Verdachtsfälle, sowie 19 bestätigte Intoxikationen von 2018-2021.
Die minimale tödliche Alpha-Chloralose-Dosis bei einer Katze liegt bei etwa 100 mg/kg Körpergewicht, beim Hund bei 600–1.000 mg/kg Körpergewicht.
Wie wirkt alpha-Chloralose?
Bei Tieren, die den Wirkstoff aufnehmen, kommt es zu einer Beeinträchtigung der Temperaturregulation und infolgedessen zu einem starken Abfall der Körpertemperatur, der letztendlich zum Tod führt. Nach Herstellerangaben sollen die Köder zur Bekämpfung von Schadnagern nur während der kalten Jahreszeiten ausgelegt und in geschlossenen Räumen verwendet werden, zu denen andere Tiere und Kinder keinen Zugang haben. Entweichen die vergifteten Nagetiere jedoch oder werden die Köder auch in der Außenwelt ausgelegt, stellen sie schnell eine Gefahrenquelle für andere Tiere dar.
Gefährliche Dosis
Bei einem durchschnittlichen Gewicht von 4 kg bei einer Hauskatze wären 10 g Köder genug, um die tödliche Dosis zu erreichen. Diese Menge kann sich ggf. schon im Magen einer vergifteten Maus befinden. Besteht der Verdacht, dass ein Tier alpha-Chloralose aufgenommen hat, oder zeigt es entsprechende Vergiftungssymptome, sollte es umgehend in einer Tierarztpraxis vorgestellt werden, um schnellstmöglich geeignete Behandlungsmaßnahmen einleiten zu können.
Vergiftungen mit alpha-Chloralose rechtzeitig erkennen
Erste Symptome einer Vergiftung mit alpha-Chloralose sind nach 30 Minuten bis 4 Stunden zu erwarten und können sich äußern in Übererregbarkeit gegenüber äußeren Reizen, Krämpfen, Muskelzittern, Bewegungsstörungen, vermehrtem Speichelfluss (v. a. beim Hund), verengten Pupillen, Abgeschlagenheit bis hin zum Koma und Atemnot. Katzen können nach dem Fressen einer vergifteten Maus Bewusstlosigkeit bis hin zu komatösen Zuständen zeigen und heftige Krämpfe entwickeln. Unkontrollierter Harn- und Kotabsatz können erste Anzeichen sein. Das Entwickeln einer Untertemperatur (< 38 °C) ist besonders typisch und wird v. a. bei Katzen beobachtet. Unbehandelt kann diese Untertemperatur zum Tod des Tieres führen und wird bei kalten Außentemperaturen beschleunigt. Besonders gefährdet sind deshalb Freigänger-Katzen, da sie eher zu spät oder gar nicht gefunden werden. Bei Hunden kann teilweise auch eine erhöhte Körpertemperatur beobachtet werden, die vermutlich durch neurologische Symptome wie Krämpfe und Muskelzittern verursacht wird.
Geeignete Behandlungsmaßnahmen
Ein Antidot gibt es nicht, daher müssen die Tiere v. a. symptomatisch behandelt werden. Liegt die vermutete Aufnahme der Substanz noch nicht lange zurück und ist das Tier bei Bewusstsein, kann ggf. Erbrechen eingeleitet oder eine Magenspülung durchgeführt werden, um den Köder bzw. das vergiftete Beutetier aus dem Magen zu eliminieren. Auch der Einsatz von Aktivkohle kann indiziert sein, um die Giftstoffe im Magen-Darm-Trakt zu binden und schneller auszuscheiden. Ansonsten sind v. a. weitere symptomatische Maßnahmen, wie Infusionen, Wärmezufuhr, ggf. Behandlung der neurologischen Symptome, essenziell. Wird die Vergiftung rechtzeitig erkannt und das Tier zeitnah behandelt, ist die Prognose für das Überleben gut bis sehr gut. Ein toxikologischer Nachweis der alpha-Chloralose, z. B. aus Serum, Urin oder Mageninhalt, ist möglich. Eine nötige Therapie sollte aber unbedingt schon vor der Bestätigung des Verdachts erfolgen.
Infoblatt zur Vergiftung mit alpha-Chloralose
Quelle (nach Angaben von):
bpt (11.04.2022). Tierärzte warnen vor Vergiftungsgefahr. Im Internet: Tierärzte warnen vor Vergiftungsgefahr: Chemisches Bekämpfungsmittel gegen Nager und Vögel gefährdet Katzen und Hunde © Bundesverband Praktizierender Tierärzte e.V. (tieraerzteverband.de). 11.04.2022
Windhal, U. et al. Alpha-chloralose poisoning in cats: Nordic Report highlights the risk of poisoning to non-target species. Copenhagen: Nordic Coucil of Ministers, 2023.